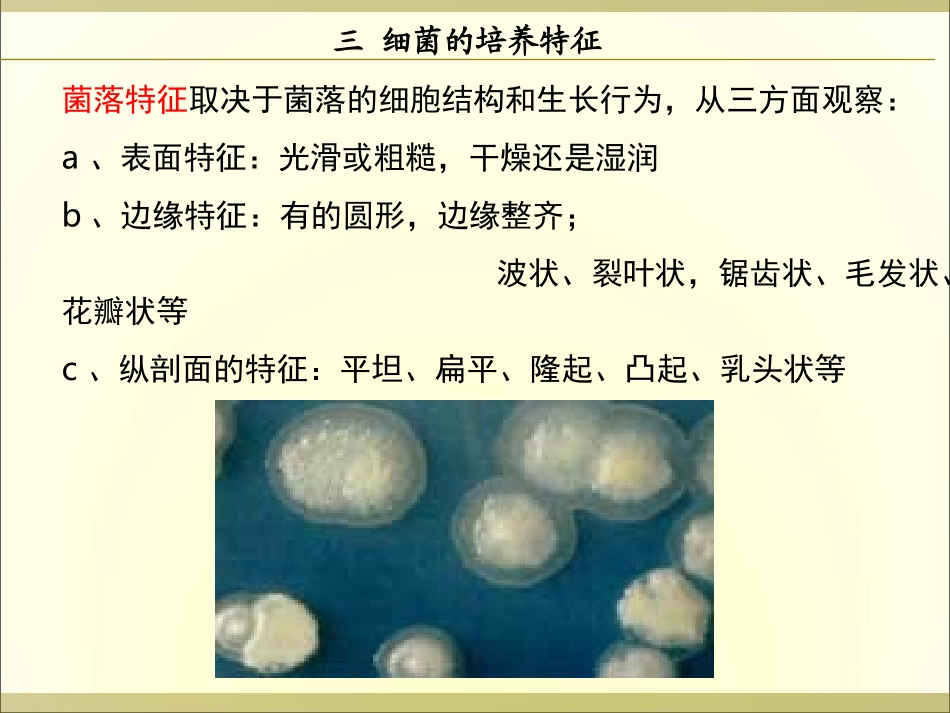
第二章 细菌(2)_第3页

三细菌的培养特征培养基:人工配制的供给微生物营养物质的基质
固体培养基(加入约1
5-2%的琼脂)半固体培养基(加入0
5%的琼脂)液体培养基明胶培养基(加入12-15%的明胶)三细菌的培养特征(一)细菌在固体培养基上的培养特征菌落:由一个细菌繁殖起来的,由无数细菌组成具有一定形态特征的细菌集团
一定条件下形成的菌落特征具有一定的稳定性和专一性,是衡量菌种纯度、辨认和鉴定菌种的重要依据
三细菌的培养特征菌落特征取决于菌落的细胞结构和生长行为,从三方面观察:a、表面特征:光滑或粗糙,干燥还是湿润b、边缘特征:有的圆形,边缘整齐;波状、裂叶状,锯齿状、毛发状、花瓣状等c、纵剖面的特征:平坦、扁平、隆起、凸起、乳头状等三细菌的培养特征纯化的菌落是菌种鉴定、通过诱变技术或基因工程改良的前提三细菌的培养特征光滑型菌落肺炎克雷伯氏菌在DHL培养基上菌落形态粘膜肺炎球菌在血琼脂平板上菌落三细菌的培养特征枯草芽孢杆菌菌落形态-粗糙型菌落三细菌的培养特征菌落的特征菌落的特征主要由各种微生物特殊的遗传特性决定主要由各种微生物特殊的遗传特性决定,,同时同时也与培养基成分及培养条件有关也与培养基成分及培养条件有关当固定培养基成分及培养条件相同时,不同种类微生物形成的菌落特征是固定的,可作为微生物鉴定的重要依据
菌菌落落形形态态三细菌的培养特征菌苔菌苔与菌落有什么不同
斜面培养基接种线上长成的一片密集的细菌群落
菌苔是由许多菌体繁殖形成
三细菌的培养特征(2)明胶培养基中的培养特征用穿刺接种法将细菌接种在明胶培养基中培养,能产生明胶水解酶水解明胶,不同的细菌将明胶水解成不同形态的溶菌区,依据这些不同形态,可将细菌进行分类
三细菌的培养特征(3)细菌在半固体培养基中的培养特征半固体培养基:含0
穿刺培养,根据细菌的生长状态判断细菌的呼吸类型和鞭毛的有无
在表面及穿刺线上